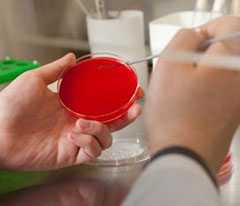
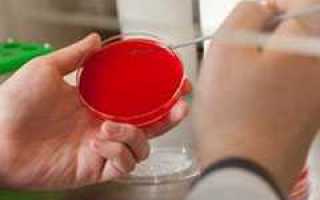

Почему приписывают такой анализ детям?
Посев мочи на стерильность детям назначают только в том случае, если предварительно был проведен общий анализ урины и врача насторожили повышенные показатели содержания эритроцитов. Бактериологический посев мочи в таком случае нужно сдавать обязательно, ведь в организме явно есть инфекция. Детям сильные антибиотики без предварительно проведенного посева мочи на бактериурию врач назначить не имеет права. После проведения терапии обязательно нужно будет повторно сдать анализ мочи на бак посев, чтобы удостоверится в результативности лечения.
Осуществляться сбор урины у детей так же, как и у взрослых: утром подмылись, собрали среднюю жидкость в стерильный контейнер и максимально быстро сдаете в лабораторию. Ели же анализ мочи на флору нужно сделать грудничку, алгоритм действий мамы такой: соберите всю мочу в мочеприемник, а потом аккуратно перелейте в контейнер. Так как организмом малыша мочи производится совсем немного, собрать среднюю жидкость практически нереально.
Хоть делается бак. посев и довольно долго, без подобного анализа современная медицина пока обойтись не может. Многих интересует вопрос, сколько делается анализ мочи на микрофлору в среднем? Ответа нет, ведь каждый случай индивидуален. Лаборант должен вырастить наибольшее количество колоний бактерий каждого типа, чтобы врач, на основе полученных результатов, смог подобрать правильное лечение.
Бакпосев мочи – эффективный и точный лабораторный анализ
Бакпосев (бактериологический посев) мочи назначают практически всем пациентам медицинских заведений. Этот анализ позволяет выявить микроорганизмы, находящиеся в моче. Такой анализ дает возможность определить наличие многих инфекционных заболеваний. При других анализах нельзя выяснить настолько точную информацию, как при бакпосеве.
Такой анализ проводится длительное время, так как для выяснения наличия бактерий в составе необходимо провести ряд опытов. Биологический материал пациента на некоторое время помещается в специальную среду, которая является благотворительной для роста и развития болезнетворных микроорганизмов.
Во время становления на учет в женскую консультацию во время беременности, женщина обязательно сдает данный анализ, чтобы убедиться в отсутствии болезнетворных микроорганизмов в мочеполовой системе. В случае обнаружения заболевания, необходимо немедленно пройти курс лечения, чтобы не нанести вреда развивающемуся плоду.
Врачи подчеркивают важность правильной подготовки к бактериологическому посеву мочи во время беременности. Для получения достоверных результатов необходимо соблюдать несколько простых, но важных правил. Во-первых, рекомендуется провести гигиеническую обработку половых органов перед сбором анализа. Это поможет избежать попадания бактерий, которые могут исказить результаты. Во-вторых, для сбора мочи следует использовать стерильный контейнер, который можно приобрести в аптеке. Важно собирать среднюю порцию мочи: начать мочеиспускание, затем на несколько секунд остановить поток и продолжить, заполняя контейнер. Анализ лучше всего сдавать утром, так как утренняя моча более концентрированная. Врачи также советуют избегать употребления антибиотиков и некоторых продуктов, таких как свекла и морковь, перед сдачей анализа, так как они могут повлиять на цвет и состав мочи. Соблюдение этих рекомендаций поможет получить точные результаты и своевременно выявить возможные инфекции, что особенно важно для здоровья матери и ребенка.
Бактериологический посев мочи — важный анализ при беременности, который помогает выявить инфекции мочевыводящих путей. Правильная подготовка к сдаче анализа играет ключевую роль. Для начала, рекомендуется провести гигиенические процедуры: тщательно вымыть половые органы, чтобы избежать загрязнения образца. Затем необходимо собрать среднюю порцию мочи: начать мочиться в унитаз, а затем, без остановки, подставить контейнер и продолжить. Это поможет получить наиболее чистый образец. Контейнер должен быть стерильным, что можно обеспечить, купив его в аптеке. После сбора мочу следует сразу же доставить в лабораторию, чтобы избежать размножения бактерий. Важно помнить, что анализ лучше сдавать утром, когда концентрация веществ в моче максимальна. Правильная сдача анализа поможет врачу назначить адекватное лечение и обеспечить здоровье как матери, так и ребенка.

Диагностирование на чувствительность к антибиотикам
Анализ на чувствительность к антибиотикам проводится в том случае, если бактерии все же обнаружены, и нужно удостовериться, что принимаемые пациентом препараты смогут побороть заболевание.
Как правильно собрать мочу, если будет проводиться анализ на бак посев именно с целью определения чувствительности к антибиотикам? Алгоритм тот же, главное, чтобы с момента окончания приема антибиотиков прошла хотя-бы неделя. Если говорить о необходимом количестве собранного материала для анализа – будет достаточно и 5 грам.
Суть исследования: чашку Петри делят на части и в каждую помещают кружок или полоску, пропитанную антибиотиком. Они маркируются по цвету или с наружной стороны чашки.
В сектора засевают выделенную чистую культуру. Чашка ставится в термостат с температурой человеческого тела. Контроль проводится ежедневно.
Идеальный антибиотик должен убить бактерии, значит, роста в секторе не будет. Но при наличии устойчивости возбудителя в отведенном участке наблюдается значительный рост колонии.
Итоги исследований указываются в заключении, а для врача считается достоверно доказанной неэффективностью препарата
Для получения результата потребуется от 4 до 5 дней. Новые экспресс-методы позволяют выполнить исследование за 2 дня, дают ответ не только по поводу чувствительных антибиотиков, но и определяют их терапевтическую дозу.
Даже при классическом выполнении анализа в случае тяжелого пациента в стационаре специалисты бак. лаборатории в состоянии дать промежуточный результат через 4 часа.
Вопрос-ответ

Как собрать мочу на бакпосев при беременности?
Cоберите мочу утром, сразу после сна, для бакпосева берётся средняя часть урины объёмом до 15 мл, биоматериал собирают в стерильную ёмкость.
Как берут анализ на бакпосев у беременных?
Сдать анализ на бакпосев при беременности Бакпосев при беременности берут из: влагалища, на предмет наличия половых инфекций, мочи, на предмет обнаружения бактерий, что очень опасно для беременных, носа, определяют наличие золотистого стафилококка.

Что нельзя делать перед бак посевом мочи?
За 10-12 часов до исследования не рекомендуется употреблять: алкоголь, острую и соленую пищу, а также пищевые продукты, изменяющие цвет мочи (свекла, морковь). По мере возможности исключить прием мочегонных препаратов.
Как берут мочу на бак посев?
Пациент собирает мочу при свободном мочеиспускании в сухую, чистую емкость с широким горлом, перемешивает и отбирает в в специальный медицинский контейнер с завинчивающейся крышкой в объеме не более 50-100 мл. Сбор мочи проводят после тщательного туалета наружных половых органов без применения антисептиков.
Советы
СОВЕТ №1
Перед сдачей анализа убедитесь, что вы правильно собрали мочу. Для этого используйте стерильный контейнер, который можно приобрести в аптеке. Необходимо собирать среднюю порцию мочи: начните мочеиспускание в туалет, затем подставьте контейнер и соберите мочу, не касаясь его краев.
СОВЕТ №2
Постарайтесь собрать мочу утром, так как в это время концентрация бактерий и других веществ в моче наиболее высока. Это поможет получить более точные результаты анализа.
СОВЕТ №3
Перед сдачей анализа рекомендуется избегать употребления антибиотиков и других лекарств, которые могут повлиять на результаты. Если вы принимаете какие-либо препараты, обязательно проконсультируйтесь с врачом о том, как это может отразиться на анализе.
СОВЕТ №4
Не забывайте о гигиенических процедурах перед сбором мочи. Тщательно промойте половые органы теплой водой без мыла, чтобы избежать загрязнения образца и получения ложноположительных результатов.